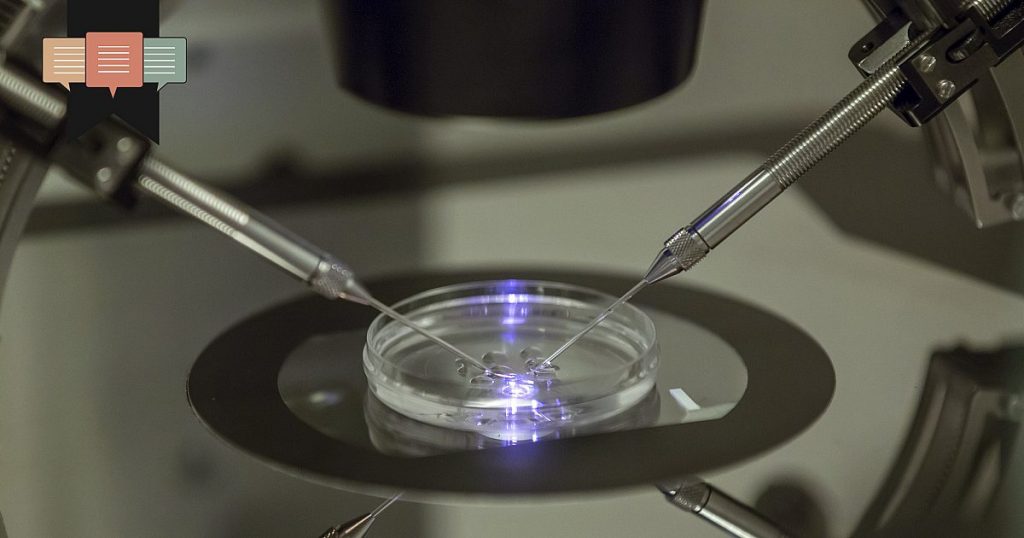
More than a mother’s pain

Krystena Murray suffered incalculable loss after medical professionals admitted to an embryo mix-up that resulted in Murray giving birth to a child who was not genetically her own. The child she bore and loved was taken from her.
Although Murray had carefully selected a sperm donor to match her blonde hair and blue eyes, she nevertheless loved the child she bore who did not have those characteristics. After taking an at-home DNA test, Murray realized she shared no DNA with her newborn son and contacted Coastal Fertility Specialists, ABC News reported.
Coastal Fertility Specialists, which operates in South Carolina and Georgia, admitted it had transferred a different couple’s embryo to Murray, according to Fox News. That couple sued for child custody, and Murray had to surrender her five-month-old baby boy in May of 2024.
“I spent my entire life wanting to be a mom,” Murray told ABC News. “I loved, nurtured, and grew my child, and I would’ve done literally anything in my power to keep him.”
Murray describes the utterly unique bond between a mother and a child that develops throughout pregnancy and birth. While modern health-care advocates attempt to deny this bond in defense of abortion and invitro fertilization, Murray’s testimony destroys their argument.
Noah Brandt, vice president of communications at Live Action, told me in an interview that stories such as Murray’s demonstrate that IVF is dangerous, unethical, and unregulated. “The story is a cautionary tale that shows that the IVF industry needs serious and immediate regulation to prevent abuses like this from happening in the future,” Brandt said.
He said the fertility company should face full punishment under the law.
“I think this company should be shut down. I don’t know how there could be a more directly abusive and negligent action from an organization like this,” Brandt said. “And unfortunately, actions like this … are not as much an outlier as we would like to think.”
Murray filed a lawsuit Feb. 18 against Coastal Fertility Specialists, which has failed to locate her embryos.
“I’ll never be the same woman,” Murray told ABC. “I will never fully heal or completely move on, and part of me will always long for my son and wonder what kind of person he’s becoming.”
Murray’s story is about more than her heartache.
Murray’s heartache depicts the utter tragedy of in vitro fertilization. IVF severs God’s beautiful design of conception, pregnancy, birth, and rearing—a process that involves a biological father and a biological mother, who are present throughout the child’s life. Every child has a right to his biological mother and father, as child-rights advocate Katy Faust argues.
That means Murray’s story is about more than her heartache. Her pain is absolutely justified but consider that little boy. He has a right to his biological mother and father, and yet he formed the maternal relationship with a woman who is not his biological mother. Now, that bond broke to restore him to genetically parental strangers.
Consider also Murray’s frozen embryos. Those lives have a biological mother, Murray, and an unknown father. And yet, most of them will likely never take a breath or meet either parent.
“The human life begins at the moment of fertilization. That’s the moment sperm fertilizes the egg,” Brandt said. “And that is literally what IVF doctors are doing. They are creating human embryos. IVF is creating and destroying and freezing millions of humans every single year.”
A focus on Murray’s pain is right but not sufficient. Her unborn children are likely forever lost. In a horrible truth, she is reaping pain from what she sowed but may never reap the joy of her children. Murray lost a child who is not her own, but she also lost others who are her own. This twisted mess is the result of what Faust calls an adult-centered mindset.
Brandt said the child should be the main consideration over of the adults.
“This is what happens when we start messing with the biological processes of creating a human life,” Brandt said. “Who does this baby rightfully go to? I think number one, the most important thing, is that the rights of the child are put first and foremost. What is the right moral, ethical choice is what is best for the child, and that needs to be discerned and investigated and ultimately acted upon.”
Children are a gift from the Lord, the Psalmist writes. Prideful human beings have distorted that gift to be an on-demand lottery. IVF sucks money, hopes, and risks—similar to the lottery’s methods. But the risk isn’t a few dollars. It’s a few million lives.